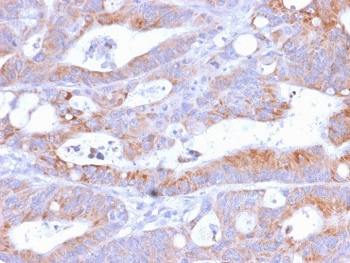
Recombinant CD86 Antibody

You have no items in your shopping cart.
CD86 Recombinant Protein
Description
Images & Validation
−| Tested Applications | WB |
|---|---|
| Application Notes |
Key Properties
−| Source | HEK293 cells |
|---|---|
| Target | CD86 |
| Tag | C-Fc Tag |
| Molecular Weight | 52 kDa |
| Protein Sequence | Ala 19 - His 240 |
| Purity | 95% as determined by SDS-PAGE. |
Storage & Handling
−| Storage | Lyophilized Protein should be stored at -20˚°C or lower for long term storage. Upon reconstitution, working aliquots should be stored at -20˚°C or -70˚°C. Avoid repeated freeze-thaw cycles. |
|---|---|
| Form/Appearance | Lyophilized |
| Buffer/Preservatives | Tris with Glycine, Arginine and NaCl, pH 7.5 |
| Disclaimer | For research use only |
Alternative Names
−Similar Products
−Human B7-2 Protein, mFc-His Tag [orb689395]
The purity of the protein is greater than 95% as determined by SDS-PAGE and Coomassie blue staining.
The protein has a predicted molecular mass of 52.4 kDa after removal of the signal peptide.
Mammalian
100 μg, 10 μg, 50 μgRecombinant CD86 Antibody [orb2640520]
ELISA, FACS, IF, IHC-P, WB
Human
Rabbit
Recombinant
Unconjugated
100 μgRecombinant CD86 Antibody / Rabbit Monoclonal [orb2640849]
FACS, IF, IHC-P, WB
Human
Rabbit
Recombinant
Unconjugated
100 μgCD86 Antibody [orb377982]
FC, IF, IHC, IP, WB
Human, Mouse, Rat
Rabbit
Polyclonal
Unconjugated
200 μl, 100 μl, 50 μl, 30 μlMouse B7-2 Protein, hFc Tag [orb1290895]
The purity of the protein is greater than 95% as determined by SDS-PAGE and Coomassie blue staining.
The protein has a predicted molecular mass of 51.4 kDa after removal of the signal peptide. The apparent molecular mass of mB7-2-hFc is approximately 55-70 kDa due to glycosylation.
Mammalian
100 μg, 10 μg, 50 μg

Quality Guarantee
Explore bioreagents carefree to elevate your research. All our products are rigorously tested for performance. If a product does not perform as described on its datasheet, our scientific support team will provide expert troubleshooting, a prompt replacement, or a refund. For full details, please see our Terms & Conditions and Buying Guide. Contact us at support@biorbyt.com.

Cynomolgus/Rhesus macaque B7-2, Fc Tag on SDS-PAGE under reducing (R) condition. The gel was stained overnight with Coomassie Blue. The purity of the protein is greater than 95%.
Documents Download
Request a Document
CD86 Recombinant Protein (orb1228143)
Participating in our Biorbyt product reviews program enables you to support fellow scientists by sharing your firsthand experience with our products.
Login to Submit a Review